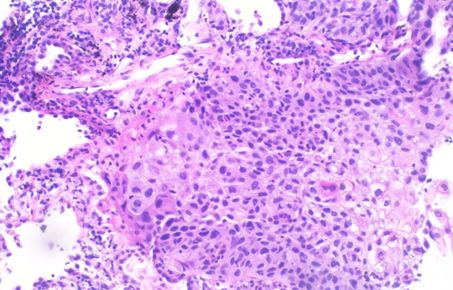

Events
Aerosols and Health seminar series
Aerosols and Health seminar series #2

26th October 2022
Aerosol transport and modelling

30th November 2022
Airborne transmission and infectious diseases
Aerosols and Health seminar series #3
14th December 2022
Airway biological toxicological responses
Back
to home page
Our
research themes